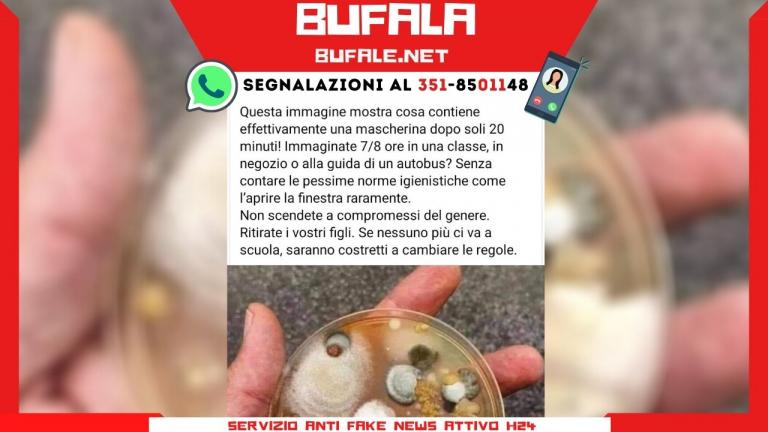

41 lettera a corrado augias
PAlingenesi: Lettera aperta a Corrado Augias Lettera aperta a Corrado Augias di Raimondo Augello. Do pubblicazione della lettera inviata in data odierna a Corrado Augias, conduttore su Rai 3 del programma Le Storie: Egregio dott. Augias, sono un telespettatore che da sempre la segue nutrendo grande ammirazione nei confronti della sua professionalità e della sua competenza. Lo scorso 13 ... Lettera a Corrado Augias da un giovane napoletano ... Lettera a Corrado Augias da un giovane napoletano, orgoglioso di esserlo. Gentile dott. Augias, mi chiamo Emilio Caserta e sono un giovane napoletano orgoglioso delle sue radici e del glorioso passato della sua gente, quel passato che non dimenticherò facilmente. Ho avuto modo di conoscerla qualche anno fa al mio caro e vecchio liceo Antonio ...
it.wikipedia.org › wiki › Alberto_Asor_RosaAlberto Asor Rosa - Wikipedia Biografia e carriera. Diplomatosi al Liceo Classico Augusto di Roma si è poi laureato alla Sapienza, relatore Natalino Sapegno.. Di formazione marxista, vicino alle posizioni operaiste di Mario Tronti, ha collaborato alle riviste Quaderni rossi, Classe operaia, Laboratorio politico e Mondo Nuovo. È stato direttore della rivista Contropiano (1968) e, dal 1990, del settimanale del PCI Rinascita.
Lettera a corrado augias
corrado augias - radiorisposta.org Lettera a Corrado Augias. Massimo Medda, 26 Aprile 2016. Sono ateo ma sono profondamente innamorato di Gesù. Così dice il noto scrittore Corrado Augias presentando in TV il suo ultimo libro Le ultime 18 ore di Gesù. corrado augias | Libero 24x7 Decisi di rendere nota la sua vicenda e lo feci con una lettera a Corrado Augias , che rispose entrando nel merito della questione del fine vita , aprendo un dibattito che durò diversi giorni e ... Corrado Augias - Wikipedia Giornalista. Corrado Augias nel 1980. Entrò in Rai nel 1960 come funzionario di fascia C. Iscritto all' Ordine dei giornalisti dal 1º aprile 1969 come giornalista professionista, ha curato le corrispondenze da New York per la RAI dal 1966 al 1968 e in seguito da Parigi per i settimanali l'Espresso e Panorama.
Lettera a corrado augias. Lettera di Walter a Corrado Augias - Associazione Walter ... Lettera a Corrado Augias. La Repubblica, 29 novembre 2014. Walter Piludu, Cagliari "Ho la Sla, voglio decidere quando morire". Caro Augias, ho 64 anni, nell'agosto del 2011 mi è stata diagnosticata la Sla. Scrivo grazie a un computer a comandi oculari. Corrado Augias e il tentativo di phishing: ecco cos'è ... Le scuse di Corrado Augias. Corrado Augias, 86 anni, ha preso un abbaglio: può capitare. Ma questo episodio mette in luce anche i rischi del web e la necessità di un'educazione digitale, considerando che le truffe sul web, secondo l'ultimo Report della Polizia Postale, sono state circa 98mila solo nel 2020. Intanto Augias, Su Repubblica di oggi 31 gennaio, ha riconosciuto l'errore: "Ieri ... Lettera a Corrado Augias da un giovane napoletano ... Decisi di rendere nota la sua vicenda e lo feci con una lettera a Corrado Augias, che rispose entrando nel merito della questione del fine vita , aprendo un dibattito che durò diversi giorni e ... Blog - Il Fatto Quotidiano - 16- 2 -2022 Lettera aperta al dott. Augias - Pontelandolfo News LETTERA DI UN GIOVANE NAPOLETANO A CORRADO AUGIAS DOPO LA TRISTE AFFERMAZIONE A "QUANTE STORIE". Gentile dott. Augias, mi chiamo Emilio Caserta e sono un giovane napoletano orgoglioso delle sue radici e del glorioso passato della sua gente, quel passato che non dimenticherò facilmente. Ho avuto modo di conoscerla qualche anno fa al mio caro …
Lettera per amore. Dialogo tra un vescovo e un ... - Avvenire Ammirevole la lettera che il vescovo Luigi Bettazzi, emerito di Ivrea, scrive a Corrado Augias, provocandolo, con amicizia, sul tema dei temi, quello di Dio e del nostro rapporto con Lui. Modello Italia - Lettere al Direttore Lettera a CORRADO AUGIAS. Caro Direttore. Ho ascoltato ieri da Floris il suo intervento sulla squallida vicenda di Caivano.Ha segnalato,a ragione, il look non propriamente infantile delpa povera Fortuna. Ma ha mai pensato che è proprio quello il "modello Italia"? Si parla pochissimo di quelle bravissime ricercatrici che accecandosi dietro ... Lettera a Corrado Augias - Radio Risposta Lettera a Corrado Augias. Massimo Medda, 26 April 2016. Sono ateo ma sono profondamente innamorato di Gesù.Così dice il noto scrittore Corrado Augias presentando in TV il suo ultimo libro Le ultime 18 ore di Gesù. Non ho letto il libro e non conosco personalmente Augias ma ho immaginato di scrivergli una lettera. A che serve studiare? Ad evadere dal ... - La Voce di New York Sempre su Facebook un suo compagno del collegio navale ha postato in suo ricordo una lettera a un giornale, direi preziosa per il messaggio universale che dà. Non so se sua, ma comunque significativa, perché non solo mi ha fatto comprendere che persona era, ma trasmette la statura morale della figura di un insegnante che temo, purtroppo, non ...
Corrado Augias truffato senza accorgersene, il web si ... Corrado Augias, raptus in diretta a Cartabianca: anche la Berlinguer resta di sasso Svelato l'inganno. La lettera, o meglio la figuraccia, ha fatto il giro della Rete. ilfatto tv - nect.it LETTERA APERTA A CORRADO AUGIAS. politica. diretta direttatv la tv italiana live canali italiani all ' estero gratis ... Scrive Nicola Zoller:Dr. Augias, un po' di equilibrio nel ... LETTERA APERTA A CORRADO AUGIAS E A " la REPUBBLICA" "Gentile dr. Corrado Augias, appena arrivato alla pagina delle lettere de "la Repubblica" domenica 10 gennaio 2021 ho avuto un ... Cosa sta succedendo a Repubblica? - Ponza ... - Ponza Racconta Ne ho scritto e torno brevemente a scriverne oggi a proposito della lettera dell'amica Patrizia a Corrado Augias, titolare della rubrica di posta. L'avevo letta in anteprima, poco prima della lettera che quel giorno (sabato 20 us) ad Augias aveva scritto un lettore. Lamentele sull'andazzo.
it.wikipedia.org › wiki › Verginità_di_MariaVerginità di Maria - Wikipedia Nell'ambito del cristianesimo, con verginità di Maria (o concepimento virginale di Gesù) si intende la dottrina secondo cui, stando alla narrazione dei Vangeli (Mt1,18-25; Lc1,26-38), Maria concepì Gesù in maniera soprannaturale per opera dello Spirito Santo, senza cioè unione carnale con un uomo.
Eutanasia, mio fratello si è ucciso per esigenza di ... Decisi di rendere nota la sua vicenda e lo feci con una lettera a Corrado Augias, che rispose entrando nel merito della questione del fine vita, aprendo un dibattito che durò diversi giorni e ...
Lettera a Corrado Augias - Lettere al Direttore Lettera a Corrado Augias. marevi. Caro Augias, la seguo da molto tempo e condivido in toto le sue idee liberali e laiche. Oggi, giornata infausta, ho mandato un commento al Corriere sulla "trionfale" ascesa di Berlusconi in campo, gliela riporto : 27.03|18:21. Sono una ex "Piccola Italiana", nata nel 1931 e ricordo le famigerate ...
disincanto politico … - orlando ... - orlando lucchetta Lettera di una lettrice a Corrado Augias: "Caro Augias, ricordo ancora la domanda che ci fece il professore di filosofia il primo giorno di Liceo: «A che serve studiare? Chi sa rispondere?» Qualcuno oso rispostine educate («A crescere bene»; «A diventare brave persone») Niente, scuoteva la testa. Finché disse: «Ad evadere dal carcere».
Corrado Augias e l'ipovisione, di Corrado Siri | Giornale UICI LETTERA A CORRADO AUGIAS. Gent. mo Dottor Augias, mi permetto di sottrarle qualche minuto, confidando nella Sua preziosa sensibilità, per sottoporre alla Sua attenzione un piccolo-GRANDE problema di natura meramente "tecnica", che personalmente (ma la cosa riguarda moltissimi altri lettori) incontro nell'affrontare la lettura della Sua rubrica "LA MIA BABELE" su IL VENERDI' di Repubblica.
Giuseppe Talia, Lettera aperta a Corrado Augias ... 24 risposte a "Giuseppe Talia, Lettera aperta a Corrado Augias. Gentilissimo Corrado Augias, Le scrivo riguardo alla trasmissione di Quante Storie su Rai3, andata in onda giorno 11 maggio 2018, dal titolo "Servono ancora i poeti?"." giorgio linguaglossa. 30 Maggio 2018 alle 8:03.
diritti dei lettori: lettere non pubblicate | Fondazione ... Questa lettera, inviata alla rubrica delle "lettere a Corrado Augias", il 21 ottobre 2020, non è stata pubblicata. Caro Augias, non si abbatta e continui la battaglia a favore della lingua italiana. Vorrei aggiungere solo due argomenti che aggravano la responsabilità di chi favorisce l'invasione di parole straniere.
Evadere dal carcere - Fino a quando... Stavamo pensando al post di oggi, quando il suggerimento ci è giunto tramite Whatsapp dalla condivisione di una vecchia lettera indirizzata a Corrado Augias qualche anno fa. Per il nostro intento non la pubblichiamo tutta intera, ma la prima parte che ci può aiutare nel condurre la riflessione di oggi.







0 Response to "41 lettera a corrado augias"
Post a Comment